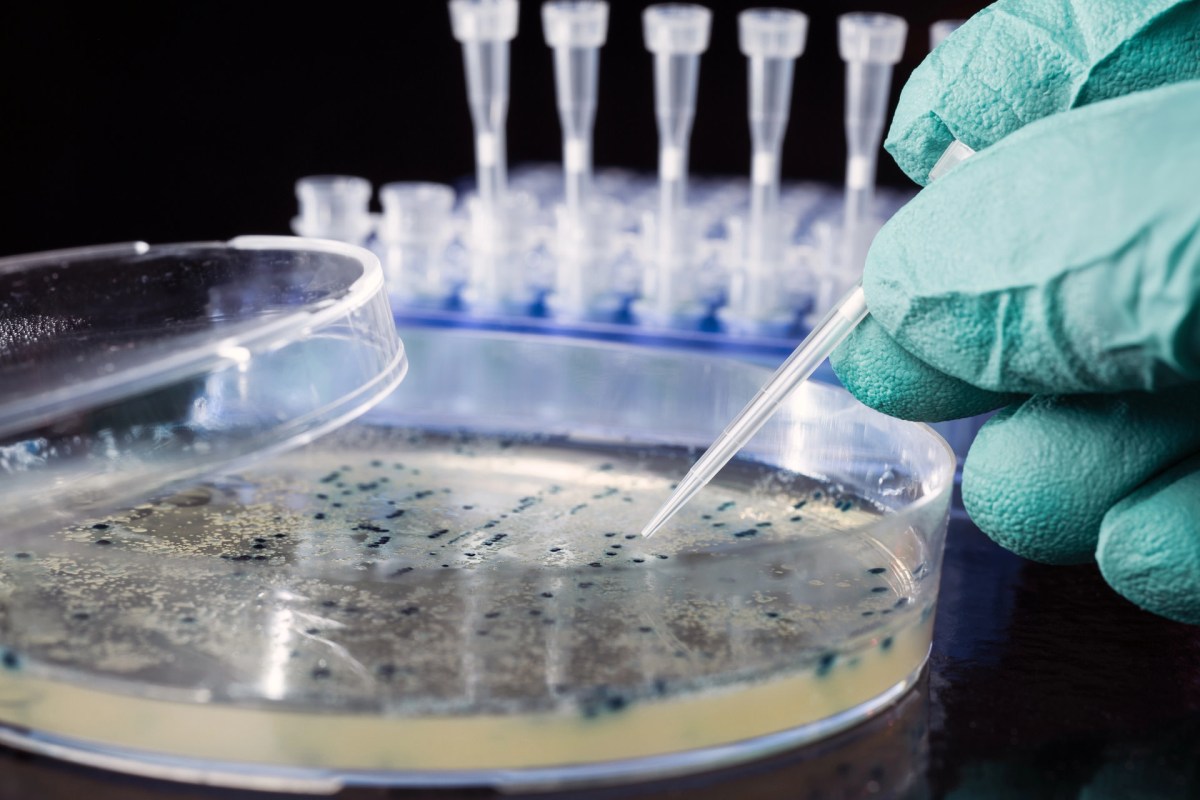

University of Illinois Urbana-Champaign scientists discovered that nanoplastics could produce mutated E. coli bacteria. Their study revealed that certain types of plastic particles cause the bacteria to create more harmful toxins. E. coli laced with toxic nanoplastics poses a major threat to the food supply and consumption.
What's happening?
Nanoplastics are small plastic fragments that are almost unavoidable. They can be in our water, food, and even our bodies. Scientists are still working to understand their full impact on our health.
Published in the Journal of Nanobiotechnology, the study showed how nanoplastics interact with E. coli O157:H7, a strain that is a common culprit in foodborne illness outbreaks.
Researchers recognized a reactionary trend: Nanoplastics with a positive surface charge are more likely to stress E. coli bacteria.
As Phys.org reported, senior study author Pratik Banerjee said, "Plastics have an enormous ability to adsorb chemicals."
His team observed this by creating nanoplastics from polystyrene. This is the same material in white Styrofoam takeout containers. They tested plastic particles with positive, neutral, and negative charges.
Save $10,000 on solar panels without even sharing your phone number Want to go solar but not sure who to trust? EnergySage has your back with free and transparent quotes from fully vetted providers that can help you save as much as $10k on installation. To get started, just answer a few questions about your home — no phone number required. Within a day or two, EnergySage will email you the best local options for your needs, and their expert advisers can help you compare quotes and pick a winner. |
Banerjee hypothesizes that surface charge will show how plastics affect a pathogenic response in E. coli.
Why are nanoplastics in E. coli concerning?
This finding is a significant concern for food safety and public health. If plastic pollution can make harmful bacteria even more potent, it increases the risk and severity of foodborne illnesses.
According to the study, E. coli forms protective layers of biofilms, but they are not enough. The positively charged nanoplastics still cause them to make more toxins.
"Biofilms are a very robust bacterial structure and are hard to eradicate. They're a big problem … in the food industry," Banerjee noted.
|
How often do you worry about the quality of your drinking water? Click your choice to see results and speak your mind. |
Beyond toxicity, other research suggests biofilms on microplastics might spread antibiotic resistance genes. This makes bacterial infections harder to treat. Pervasive plastic pollution could have many cascading negative effects on human health.
What's being done about toxic, foodborne nanoplastics?
This research is a crucial step in understanding the complex interactions between plastics and pathogens. Banerjee's group is continuing to study these effects, including how nanoplastics might alter the transmission of foodborne pathogens in food and other environments.
To prevent nanoplastics, we have to reduce plastic production and consumption. The amount of nanoplastics entering our environment and food chain is immense. However, there are still a few solutions.
Supporting policies aimed at cutting plastic waste prioritizes community safety and ensures corporate responsibility. Investing in plastic-free or sustainable alternatives to plastic packaging provides better food safety. Individuals can use less plastic with reusable containers, bags, and water bottles.
Reducing plastics is key to protecting our food supply and overall health. Businesses and consumers can begin solving the issue by limiting their exposure.
Join our free newsletter for weekly updates on the latest innovations improving our lives and shaping our future, and don't miss this cool list of easy ways to help yourself while helping the planet.